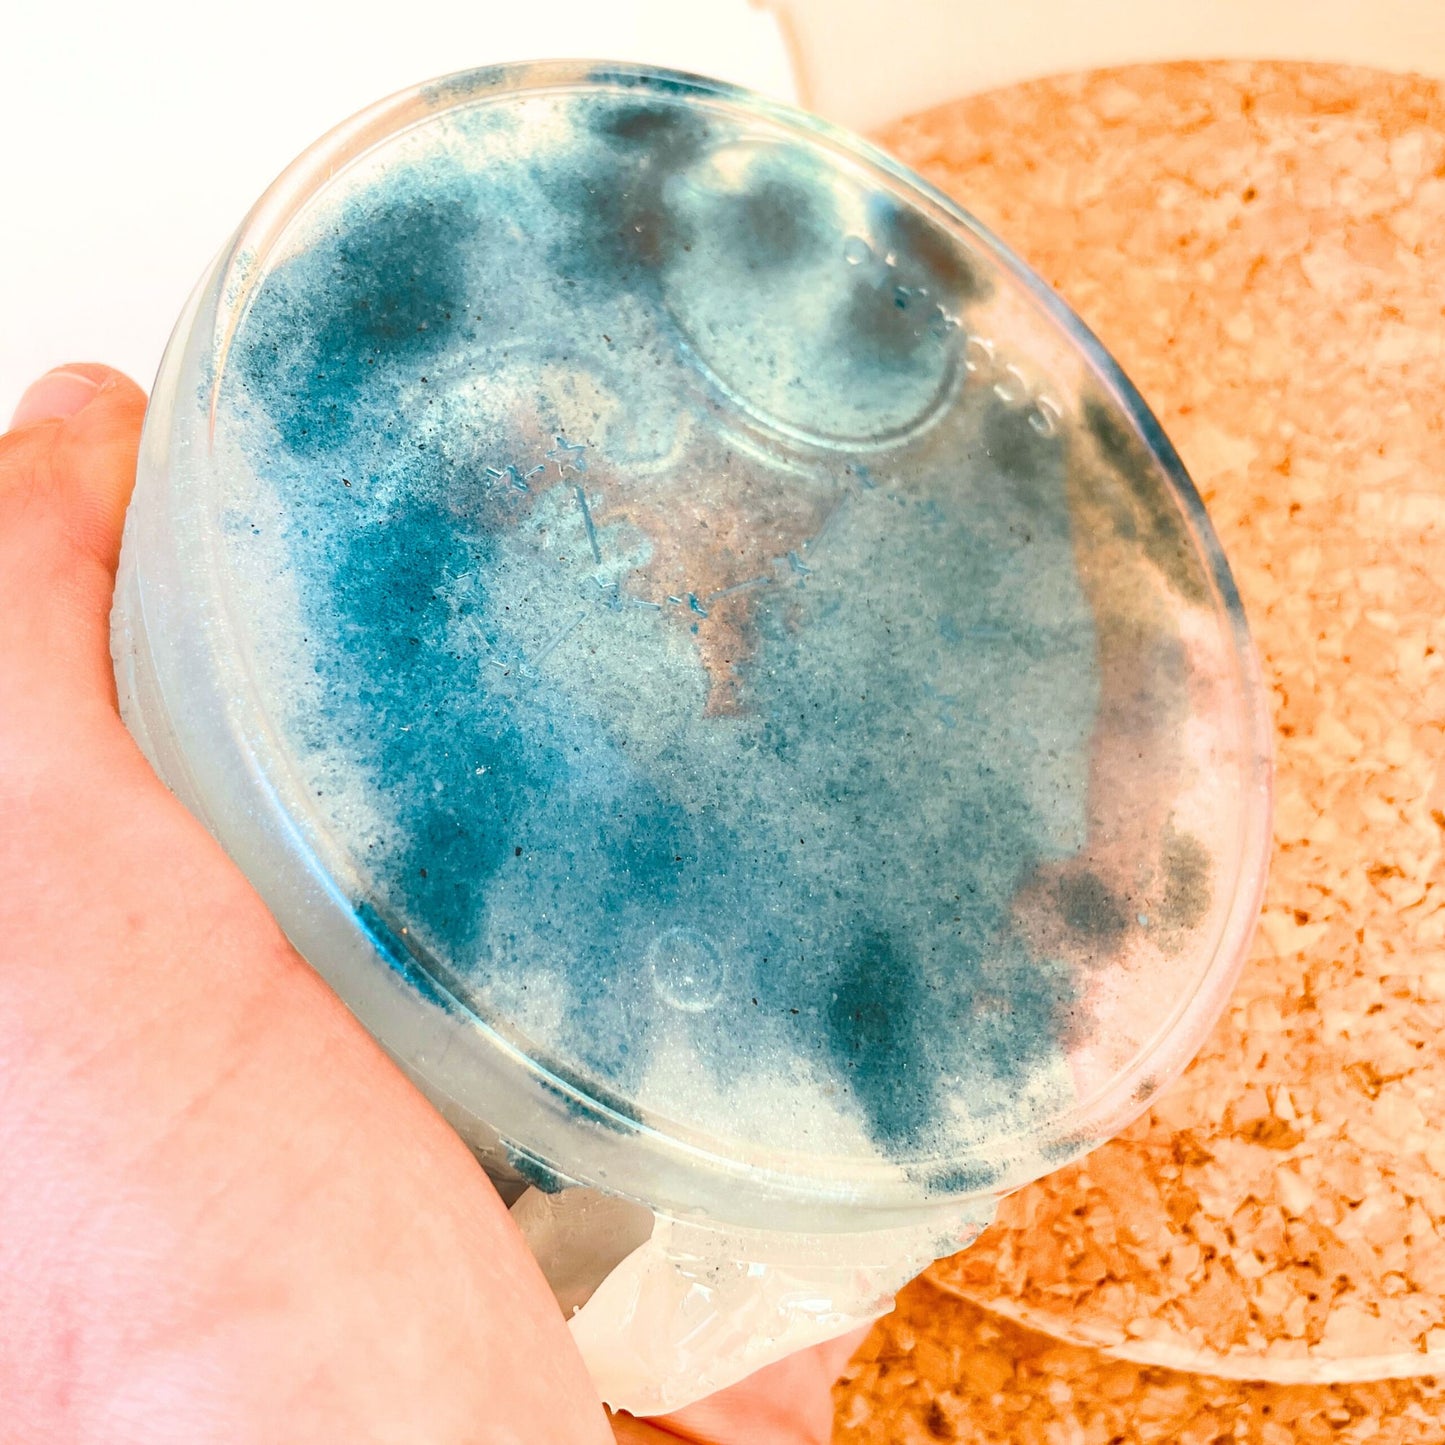
SteamVoyage - porta candele del drago sommerso in resina epossidica

SteamVoyage
Sunken Dragon Candle Holder
Sunken Dragon Candle Holder
Couldn't load pickup availability
The Sunken Dragon Candle Holder is a handcrafted accessory designed for all lovers of role-playing games and fantasy. Original and elegant, it blends beautifully with any decor style and draws attention.
Made of semi-transparent epoxy resin with mineral or stone inserts, the sunken dragon watches over the candle holder with its watchful gaze. The candle is easily replaceable, making the Sunken Dragon Candle Holder the perfect handcrafted accessory to brighten up your Dungeons & Dragons sessions or board games, especially detective games!
If you have a different color in mind, please contact us: the Sunken Dragon Candle Holder can be made in any color and with any type of insert; the limit is your imagination.
Main features:
- Base diameter - 10 cm
- Aluminum candle holder diameter - 2.5 cm
- Copper candle holder diameter - 2 cm
- Maximum dragon height - 4 cm
- Weight - 160 g to 180 g depending on the model and inserts
- Materials - Epoxy resin with or without stone or salt inserts; aluminum or copper candle holder; wax candle
Impress your guests with the Sunken Dragon Candle Holder: a unique, colorful and elegant handcrafted object perfect for all role-playing or tabletop players and for those who love to decorate their home in a fantasy style.
Share